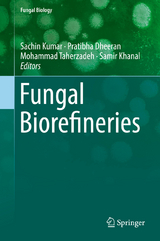
Fungal Biorefineries -

Fungal Biorefineries (eBook)
246 Seiten
Springer International Publishing (Verlag)
978-3-319-90379-8 (ISBN)
Dr. Sachin Kumar is a Deputy Director in the Biochemical Conversion Division at the Sardar Swaran Singh National Institute of Bio-Energy, Kapurthala, India. He was as a Visiting Professor in the Department of Chemical and Biological Engineering at South Dakota School of Mines and Technology, Rapid City, USA for a year. He obtained his Ph.D. in Chemical Engineering from Indian Institute of Technology, Roorkee, India and has more than twelve years of research experience in Biochemical Conversion of Biomass to Biofuels including lignocellulosic ethanol, biogas, biohydrogen, etc. He has completed six research projects and one consultancy project and actively engaged in two on-going research projects. Dr. Sachin has published more than 45 papers in peer reviewed journals, book chapters and papers in conference proceedings and 7 edited books. He has one granted US patent and one filed Indian patent. He has delivered more than 15 invited/plenary lectures and presented more than 60 papers in national and international conferences. He is a recipient of 2016 ASM-IUSSTF Indo-US Research Professorship and selected as Bioenergy-Awards for Cutting Edge Research (B-ACER) Fellow 2016 by DBT and IUSSTF. Dr. Pratibha Dheeran is working as an Assistant Professor in the Department of Botany, Maharaj Singh College, Saharanpur, India. Dr. Dheeran has Ph.D. degree in Biochemistry from Jiwaji University, Gwalior/Indian Institute of Petroleum, Dehradun India. She has master degree in Biotechnology from Indian Institute of Technology, Roorkee and MSc in Botany from Chaudhary Charan Singh University Meerut. She has been awarded DST Fast Track Young Scientist Grant by Department of Science and Technology, India. She is a recipient of Innovation Postdoctoral Fellowship by Cape Peninsula University of Technology Cape Town, South Africa. Dr. Dheeran has eight years of research experience in Biocatalysis, Thermophilic microbiology and Biofuels. She has eight research papers in various peer-reviewed journals, three book chapters and three conference proceedings. Dr. Mohammad Taherzadeh is professor in Bioprocess technology since 2004 at University of Borås in Sweden and director of the research school at Swedish Centre for Resource Recovery. Prof. Taherzadeh has PhD in Bioscience from Sweden, and MSc and BSc in Chemical Engineering from Iran. He is developing processes to convert wastes and residuals to value added products such as ethanol, biogas, human food, animal feed, and biopolymers by fermentation. He has worked with filamentous fungi since 1999 and has many publications on industrial applications of the fungi and developing fungal-based biorefineries. He has more than 220 publications in scientific peer-reviewed journals, 19 book chapters, 5 patents and 3 books. Dr. Samir Kumar Khanal is an Associate Professor of Biological Engineering at the University of Hawai‘i at Mānoa. Dr. Khanal is a leading researcher, internationally in the field of anaerobic digestion, waste-to-resources and environmental biotechnology. He wrote and published a book entitled “Anaerobic Biotechnology for Bioenergy Production: Principles and Applications” (Wiley-Blackwell, 2008, Bestseller). Recently he also published a bioenergy textbook entitled Bioenergy: Principles and Application (Wiley-Blackwell, 2016). Dr. Khanal is an Associate Editor of Bioresource Technology. He is a recipient of CTAHR Dean’s Award for Excellence in Research (2016), University of Hawaii at Manoa.
Chapter 1 Role of Fungi in Biorefinery: A Perspective
Kanika Chowdhary, Usha Prasad, Satyawati Sharma
Chapter 2 Production of Biofuels from Biomass by Fungi
Gail Joseph, Lijun Wang
Chapter 3 White-rot Fungal Xylanases for Applications in Pulp and Paper industry
Shalini Singh
Chapter 4 Fungal Enzymes Applied to Industrial Processes for Bioethanol Production
Cecilia Laluce, Kelly J. Dussán, Marisa V. Capella
Chapter 5 Economical Lactic Acid Production and Optimization Strategies
Sheelendra M. Bhatt
Chapter 6 Exploiting Innate and Imported Fungal Capacity for Xylitol Production
Shaik Jakeer
Chapter 7 Insights into Fungal Xylose Reductases and its Application in Xylitol Production
Yogita Lugani, Balwinder Singh Sooch
Chapter 8 Single Cell Oils (SCOs) of Oleaginous Filamentous Fungi as a Renewable Feedstock: A Biodiesel Biorefinery Approach
Mahesh Khot, Gouri Katre, Smita Zinjarde, Ameeta RaviKumar
Chapter 9 Fungal Biorefinery for the Production of Single Cell Oils as Advanced Biofuels
Abu Yousuf, Baranitharan Ethiraj, Maksudur Rahman Khan, Domenico Pirozzi
Chapter 10 Production of Single Cell Protein (SCP) from Vinasse
Ernesto Acosta Martínez, Jéssica Ferreira dos Santos, Geiza Suzart Araujo, Sílvia Maria Almeida de Souza, Rita de Cássia Lacerda Brambilla Rodrigues, and Eliana Vieira Canettieri
| Erscheint lt. Verlag | 4.7.2018 |
|---|---|
| Reihe/Serie | Fungal Biology | Fungal Biology |
| Zusatzinfo | XIV, 246 p. 32 illus., 27 illus. in color. |
| Verlagsort | Cham |
| Sprache | englisch |
| Themenwelt | Naturwissenschaften ► Biologie ► Genetik / Molekularbiologie |
| Naturwissenschaften ► Biologie ► Mikrobiologie / Immunologie | |
| Schlagworte | advanced biofuels • hydrolytic enzymes • organic acids • Polyols • secondary metabolites • systematic botany |
| ISBN-10 | 3-319-90379-9 / 3319903799 |
| ISBN-13 | 978-3-319-90379-8 / 9783319903798 |
| Informationen gemäß Produktsicherheitsverordnung (GPSR) | |
| Haben Sie eine Frage zum Produkt? |
DRM: Digitales Wasserzeichen
Dieses eBook enthält ein digitales Wasserzeichen und ist damit für Sie personalisiert. Bei einer missbräuchlichen Weitergabe des eBooks an Dritte ist eine Rückverfolgung an die Quelle möglich.
Dateiformat: PDF (Portable Document Format)
Mit einem festen Seitenlayout eignet sich die PDF besonders für Fachbücher mit Spalten, Tabellen und Abbildungen. Eine PDF kann auf fast allen Geräten angezeigt werden, ist aber für kleine Displays (Smartphone, eReader) nur eingeschränkt geeignet.
Systemvoraussetzungen:
PC/Mac: Mit einem PC oder Mac können Sie dieses eBook lesen. Sie benötigen dafür einen PDF-Viewer - z.B. den Adobe Reader oder Adobe Digital Editions.
eReader: Dieses eBook kann mit (fast) allen eBook-Readern gelesen werden. Mit dem amazon-Kindle ist es aber nicht kompatibel.
Smartphone/Tablet: Egal ob Apple oder Android, dieses eBook können Sie lesen. Sie benötigen dafür einen PDF-Viewer - z.B. die kostenlose Adobe Digital Editions-App.
Buying eBooks from abroad
For tax law reasons we can sell eBooks just within Germany and Switzerland. Regrettably we cannot fulfill eBook-orders from other countries.
aus dem Bereich